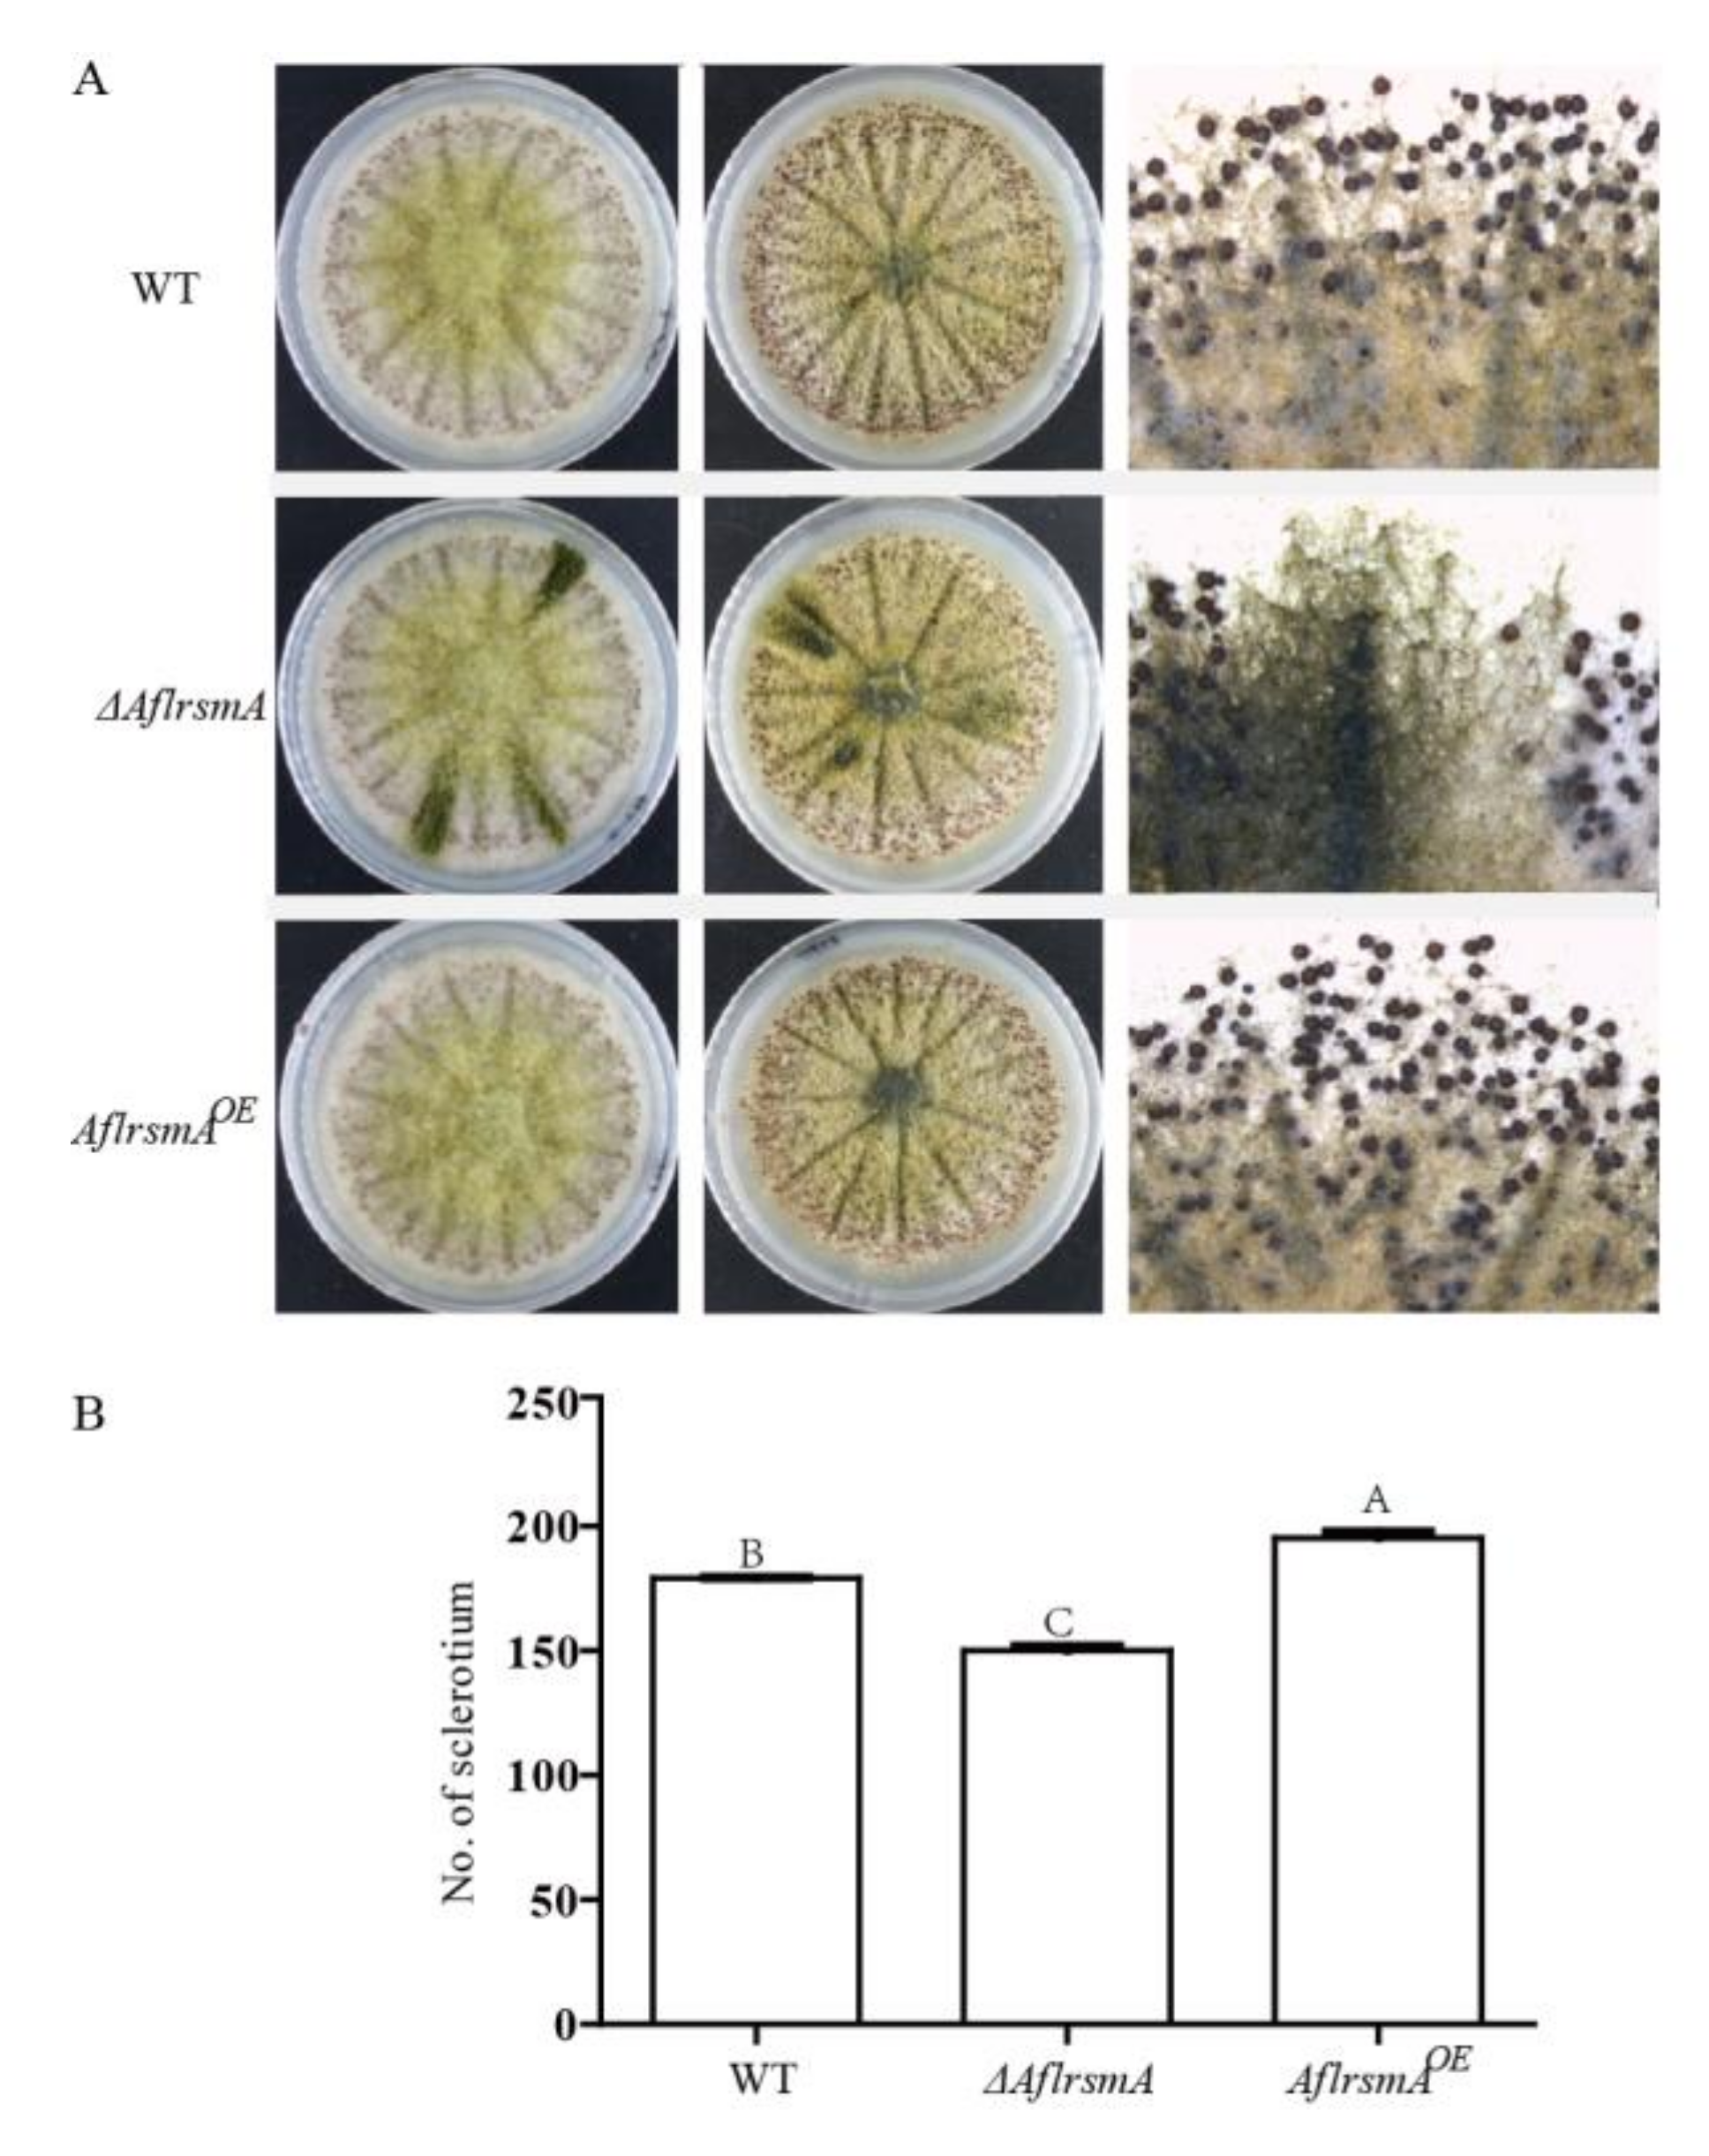

The bZIP Transcription Factor AflRsmA Regulates Aflatoxin B1 Biosynthesis, Oxidative Stress Response and Sclerotium Formation in Aspergillus flavus
Abstract
1. Introduction
2. Results
2.1. Identification and Phylogenetic Analysis of AflRsmA, a RsmA ortholog in A. flavus
2.2. Expression of AflrsmA and Creation of AflrsmA Mutant
2.3. AflRsmA Responses to Oxidative Stress in A. flavus
2.4. AflRsmA Involved in AFB1 Production is Oxidative Stress Related
2.5. AflRsmA Positively Regulates Sclerotia Formation
2.6. AflrsmA is a Positive Regulator of Virulence toward Corn
3. Discussion
4. Materials and Methods
4.1. Strains, Media and Culture Conditions
4.2. Identification, Phylogentic Analysis and Domain Prediction of AflrsmA
4.3. RNA Extraction of A. flavus and Reverse Transcription-Polymerase Chain Reaction (RT-PCR) of AflrsmA
4.4. Creation of AflrsmA Mutant Strains
4.5. Oxidative Stress Susceptibility of A. flavus Mutants
4.6. Analysis of Aflatoxin B1 Produced by A. flavus
4.7. Assay for Sclerotia Production
4.8. Corn Infection and Aflatoxin Extraction from Seed
4.9. Statistical Analysis
Author Contributions
Funding
Conflicts of Interest
References
- Fungal Transcription Factor Database (FTFD 1.2) program. Available online: http://ftfd.snu.ac.kr/index.php?a=view (accessed on 1 February 2020).
- Amoutzias, G.D.; Veron, A.S.; Weiner, J.; Robinson-Rechavi, M.; Bornberg-Bauer, E.; Oliver, S.G.; Robertson, D.L. One billion years of bZIP transcription factor evolution: Conservation and change in dimerization and DNA-binding site specificity. Mol. Biol. Evol. 2007, 24, 827–835. [Google Scholar] [CrossRef] [PubMed]
- Llorca, C.M.; Potschin, M.; Zentgraf, U. bZIPs and WRKYs: Two large transcription factor families executing two different functional strategies. Front. Plant Sci. 2014, 5, 169. [Google Scholar] [CrossRef]
- Moye-Rowley, W.S.; Harshman, K.D.; Parker, C.S. Yeast YAP1 encodes a novel form of the jun family of transcriptional activator proteins. Genes Dev. 1989, 3, 283–292. [Google Scholar] [CrossRef] [PubMed]
- Fernandes, L.; Rodrigues-Pousada, C.; Struhl, K. Yap, a novel family of eight bZIP proteins in Saccharomyces cerevisiae with distinct biological functions. Mol. Cell. Biol. 1997, 17, 6982–6993. [Google Scholar] [CrossRef] [PubMed]
- Yin, W.B.; Reinke, A.W.; Szilágyi, M.; Emri, T.; Chiang, Y.M.; Keating, A.E.; Pócsi, I.; Wang, C.C.; Keller, N.P. bZIP transcription factors affecting secondary metabolism, sexual development and stress responses in Aspergillus nidulans. Microbiology 2013, 159, 77–88. [Google Scholar] [CrossRef]
- Balázs, A.; Pócsi, I.; Hamari, Z.; Leiter, E.; Emri, T.; Miskei, M.; Oláh, J.; Tóth, V.; Hegedus, N.; Prade, R.A.; et al. AtfA bZIP-type transcription factor regulates oxidative and osmotic stress responses in Aspergillus nidulans. Mol. Genet. Genom. 2010, 283, 289–303. [Google Scholar] [CrossRef]
- Qiao, J.; Kontoyiannis, D.P.; Calderone, R.; Li, D.; Ma, Y.; Wan, Z.; Li, R.; Liu, W. Afyap1, encoding a bZip transcriptional factor of Aspergillus fumigatus, contributes to oxidative stress response but is not essential to the virulence of this pathogen in mice immunosuppressed by cyclophosphamide and triamcinolone. Med. Mycol. 2008, 46, 773–782. [Google Scholar] [CrossRef][Green Version]
- Reverberi, M.; Zjalic, S.; Punelli, F.; Ricelli, A.; Fabbri, A.A.; Fanelli, C. Apyap1 affects aflatoxin biosynthesis during Aspergillus parasiticus growth in maize seeds. Food Addit. Contam. 2007, 24, 1070–1075. [Google Scholar] [CrossRef]
- Reverberi, M.; Gazzetti, K.; Punelli, F.; Scarpari, M.; Zjalic, S.; Ricelli, A.; Fabbri, A.A.; Fanelli, C. Aoyap1 regulates OTA synthesis by controlling cell redox balance in Aspergillus ochraceus. Appl. Microbiol. Biotechnol. 2012, 95, 1293–1304. [Google Scholar] [CrossRef]
- Roze, L.V.; Chanda, A.; Wee, J.; Awad, D.; Linz, J.E. Stress-related transcription factor AtfB integrates secondary metabolism with oxidative stress response in aspergilli. J. Biol. Chem. 2011, 286, 35137–35148. [Google Scholar] [CrossRef]
- Tian, C.; Li, J.; Glass, N.L. Exploring the bZIP transcription factor regulatory network in Neurospora crassa. Microbiology 2011, 157, 747–759. [Google Scholar] [CrossRef] [PubMed]
- Wang, Y.; Liu, W.; Hou, Z.; Wang, C.; Zhou, X.; Jonkers, W.; Ding, S.; Kistler, H.C.; Xu, J.R. A novel transcriptional factor important for pathogenesis and ascosporogenesis in Fusarium graminearum. Mol. Plant Microbe Interact. 2011, 24, 118–128. [Google Scholar] [CrossRef] [PubMed]
- Guo, M.; Chen, Y.; Du, Y.; Dong, Y.; Guo, W.; Zhai, S.; Zhang, H.; Dong, S.; Zhang, Z.; Wang, Y.; et al. The bZIP transcription factor MoAP1 mediates the oxidative stress response and is critical for pathogenicity of the rice blast fungus Magnaporthe oryzae. PLoS Pathog. 2011, 7, e1001302. [Google Scholar] [CrossRef] [PubMed]
- Fang, Y.; Xiong, D.; Tian, L.; Tang, C.; Wang, Y.; Tian, C. Functional characterization of two bZIP transcription factors in Verticillium dahliae. Gene 2017, 626, 386–394. [Google Scholar] [CrossRef]
- Cartwright, G.M.; Scott, B. Redox regulation of an AP-1-like transcription factor, YapA, in the fungal symbiont Epichloë festucae. Eukaryot. Cell 2013, 12, 1335–1348. [Google Scholar] [CrossRef][Green Version]
- Wang, X.; Wu, F.; Liu, L.; Liu, X.; Che, Y.; Keller, N.P.; Guo, L.; Yin, W.B. The bZIP transcription factor PfZipA regulates secondary metabolism and oxidative stress response in the plant endophytic fungus Pestalotiopsis fici. Fungal Genet. Biol. 2015, 81, 221–228. [Google Scholar] [CrossRef]
- Sekonyela, R.; Palmer, J.M.; Bok, J.W.; Jain, S.; Berthier, E.; Forseth, R.; Schroeder, F.; Keller, N.P. RsmA regulates Aspergillus fumigatus gliotoxin cluster metabolites including cyclo(L-Phe-L-Ser), a potential new diagnostic marker for invasive aspergillosis. PLoS ONE 2013, 8, e62591. [Google Scholar] [CrossRef]
- Huang, W.; Shang, Y.; Chen, P.; Cen, K.; Wang, C. Basic leucine zipper (bZIP) domain transcription factor MBZ1 regulates cell wall integrity, spore adherence, and virulence in Metarhizium robertsii. J. Biol. Chem. 2015, 290, 8218–8231. [Google Scholar] [CrossRef]
- Ye, W.; Wang, Y.; Dong, S.; Tyler, B.M.; Wang, Y. Phylogenetic and transcriptional analysis of an expanded bZIP transcription factor family in Phytophthora sojae. BMC Genom. 2013, 14, 839. [Google Scholar] [CrossRef]
- Navarro, P.; Billette, C.; Ferrer, N.; Savoie, J.M. Characterization of the aap1 gene of Agaricus bisporus, a homolog of the yeast YAP1. Comptes Rendus Boil. 2014, 337, 29–43. [Google Scholar] [CrossRef] [PubMed]
- Shaaban, M.I.; Bok, J.W.; Lauer, C.; Keller, N.P. Suppressor mutagenesis identifies a velvet complex remediator of Aspergillus nidulans secondary metabolism. Eukaryot. Cell 2010, 9, 1816–1824. [Google Scholar] [CrossRef] [PubMed]
- Yin, W.B.; Amaike, S.; Wohlbach, D.J.; Gasch, A.P.; Chiang, Y.M.; Wang, C.C.; Bok, J.W.; Rohlfs, M.; Keller, N.P. An Aspergillus nidulans bZIP response pathway hardwired for defensive secondary metabolism operates through aflR. Mol. Microbiol. 2012, 83, 1024–1034. [Google Scholar] [CrossRef] [PubMed]
- Tang, W.; Ru, Y.; Hong, L.; Zhu, Q.; Zuo, R.; Guo, X.; Wang, J.; Zhang, H.; Zheng, X.; Wang, P.; et al. System-wide characterization of bZIP transcription factor proteins involved in infection-related morphogenesis of Magnaporthe oryzae. Environ. Microbiol. 2015, 17, 1377–1396. [Google Scholar] [CrossRef] [PubMed]
- Kong, S.; Park, S.Y.; Lee, Y.H. Systematic characterization of the bZIP transcription factor gene family in the rice blast fungus, Magnaporthe oryzae. Environ. Microbiol. 2015, 17, 1425–1443. [Google Scholar] [CrossRef]
- Klich, M.A. Aspergillus flavus: The major producer of aflatoxin. Mol. Plant Pathol. 2007, 8, 713–722. [Google Scholar] [CrossRef] [PubMed]
- Amaike, S.; Keller, N.P. Aspergillus flavus. Annu. Rev. Phytopathol. 2011, 49, 107–133. [Google Scholar] [CrossRef]
- Calvo, A.M.; Cary, J.W. Association of fungal secondary metabolism and sclerotial biology. Front. Microbiol. 2015, 6, 62. [Google Scholar] [CrossRef]
- Hong, S.Y.; Roze, L.V.; Linz, J.E. Oxidative stress-related transcription factors in the regulation of secondary metabolism. Toxins 2013, 5, 683–702. [Google Scholar] [CrossRef]
- Amaike, S.; Affeldt, K.J.; Yin, W.B.; Franke, S.; Choithani, A.; Keller, N.P. The bZIP protein MeaB mediates virulence attributes in Aspergillus flavus. PLoS ONE 2013, 8, e74030. [Google Scholar] [CrossRef] [PubMed]
- Guan, X.; Zhao, Y.; Liu, X.; Shang, B.; Xing, F.; Zhou, L.; Wang, Y.; Zhang, C.; Bhatnagar, D.; Liu, Y. The bZIP transcription factor Afap1 mediates the oxidative stress response and aflatoxin biosynthesis in Aspergillus flavus. Rev. Argent. Microbiol. 2019, 51, 292–301. [Google Scholar] [CrossRef] [PubMed]
- Ukai, Y.; Kuroiwa, M.; Kurihara, N.; Naruse, H.; Homma, T.; Maki, H.; Naito, A. Contributions of yap1 mutation and subsequent atrF upregulation to voriconazole resistance in Aspergillus flavus. Antimicrob. Agents Chemother. 2018, 62, e01216–e01218. [Google Scholar] [CrossRef] [PubMed]
- Caceres, I.; El Khoury, R.; Bailly, S.; Oswald, I.P.; Puel, O.; Bailly, J.D. Piperine inhibits aflatoxin B1 production in Aspergillus flavus by modulating fungal oxidative stress response. Fungal Genet. Biol. 2017, 107, 77–85. [Google Scholar] [CrossRef] [PubMed]
- Payne, G.A.; Nierman, W.C.; Wortman, J.R.; Pritchard, B.L.; Brown, D.; Dean, R.A.; Bhatnagar, D.; Cleveland, T.E.; Machida, M.; Yu, J. Whole genome comparison of Aspergillus flavus and A. oryzae. Med. Mycol. 2006, 44, S9–S11. [Google Scholar] [CrossRef] [PubMed]
- SoftBerry software. Available online: http://linux1.softberry.com/berry.phtml (accessed on 20 May 2018).
- EBI Web server. Available online: https://www.ebi.ac.uk/Tools/services/web/toolform.ebi?tool=iprscan5&sequence=uniprot:KPYM_HUMAN (accessed on 14 July 2018).
- Coley-Smith, J.R.; Cooke, R.C. Survival and germination of fungal sclerotia. Annu. Rev. Phytopathol. 1971, 9, 65–92. [Google Scholar] [CrossRef]
- Liu, L. Bioactive metabolites from the plant endophyte Pestalotiopsis fici. Mycology 2011, 2, 37–45. [Google Scholar] [CrossRef]
- Chang, P.K.; Ehrlich, K.C.; Yu, J.J.; Bhatnagar, D.; Cleveland, T.E. Increased expression of Aspergillus parasiticus AflR, encoding a sequence-specific DNA-binding protein, relieves nitrate inhibition of aflatoxin biosynthesis. Appl. Environ. Microbiol. 1995, 61, 2372–2377. [Google Scholar] [CrossRef] [PubMed]
- Fernandes, M.; Keller, N.P.; Adams, T.H. Sequence-specific binding by Aspergillus nidulans AflR, a C6 zinc cluster protein regulating mycotoxin biosynthesis. Mol. Microbiol. 1998, 28, 1355–1365. [Google Scholar] [CrossRef]
- Reverberi, M.; Zjalic, S.; Ricelli, A.; Punelli, F.; Camera, E.; Fabbri, C.; Picardo, M.; Fanelli, C.; Fabbri, A.A. Modulation of antioxidant defense in Aspergillus parasiticus is involved in aflatoxin biosynthesis: A role for the ApyapA gene. Eukaryot. Cell 2008, 7, 988–1000. [Google Scholar] [CrossRef]
- Toledano, M.B.; Delaunay, A.; Biteau, B.; Spector, D.; Azevedo, D. Oxidative stress responses in yeast. In Yeast Stress Responses; Hohman, S., Mager, W.H., Eds.; Springer-Verlag: Berlin, Germany, 2003; pp. 305–387. [Google Scholar]
- Masaki, N.; Kyle, M.E.; Farber, J.L. tert-Butyl hydroperoxide kills cultured hepatocytes by peroxidizing membrane lipids. Arch. Biochem. Biophys. 1989, 269, 390–399. [Google Scholar] [CrossRef]
- Reverberi, M.; Ricelli, A.; Zjalic, S.; Fabbri, A.A.; Fanelli, C. Natural functions of mycotoxins and control of their biosynthesis in fungi. Appl. Microbiol. Biotechnol. 2010, 87, 899–911. [Google Scholar] [CrossRef]
- Roze, L.V.; Hong, S.Y.; Linz, J.E. Aflatoxin biosynthesis: Current frontiers. Annu. Rev. Food Sci. Technol. 2013, 4, 293–311. [Google Scholar] [CrossRef] [PubMed]
- Hong, S.Y.; Roze, L.V.; Wee, J.; Linz, J.E. Evidence that a transcription factor regulatory network coordinates oxidative stress response and secondary metabolism in aspergilli. Microbiol. Open 2013, 2, 144–160. [Google Scholar] [CrossRef] [PubMed]
- Jayashree, T.; Subramanyam, C. Oxidative stress as a prerequisite for aflatoxin production by Aspergillus parasiticus. Free Radic. Biol. Med. 2000, 29, 981–985. [Google Scholar] [CrossRef]
- Zhang, F.; Xu, G.; Geng, L.; Lu, X.; Yang, K.; Yuan, J.; Nie, X.; Zhuang, Z.; Wang, S. The stress response regulator AflSkn7 influences morphological development, stress response, and pathogenicity in the fungus Aspergillus flavus. Toxins 2016, 8, E202. [Google Scholar] [CrossRef] [PubMed]
- Fasoyin, O.E.; Yang, K.; Qiu, M.; Wang, B.; Wang, S.; Wang, S. Regulation of morphology, aflatoxin production, and virulence of Aspergillus flavus by the major nitrogen regulatorygene are A. Toxins 2019, 11, E718. [Google Scholar] [CrossRef] [PubMed]
- Walther, A.; Wendland, J. Yap1-dependent oxidative stress response provides a link to riboflavin production in Ashbya gossypii. Fungal Genet. Biol. 2012, 49, 697–707. [Google Scholar] [CrossRef]
- Montibus, M.; Ducos, C.; Bonnin-Verdal, M.N.; Bormann, J.; Ponts, N.; Richard-Forget, F.; Barreau, C. The bZIP transcription factor Fgap1 mediates oxidative stress response and trichothecene biosynthesis but not virulence in Fusarium graminearum. PLoS ONE 2013, 8, e83377. [Google Scholar] [CrossRef]
- Calvo, A.M.; Wilson, R.A.; Bok, J.W.; Keller, N.P. Relationship between secondary metabolism and fungal development. Microbiol. Mol. Biol. Rev. 2002, 66, 447–459. [Google Scholar] [CrossRef]
- Calvo, A.M. The VeA regulatory system and its role in morphological and chemical development in fungi. Fungal Genet. Biol. 2008, 45, 1053–1061. [Google Scholar] [CrossRef]
- Duran, R.M.; Cary, J.W.; Calvo, A.M. Production of cyclopiazonic acid, aflatrem, and aflatoxin by Aspergillus flavus is regulated by veA, a gene necessary for sclerotial formation. Appl. Microbiol. Biotechnol. 2007, 73, 1158–1168. [Google Scholar] [CrossRef]
- Duran, R.M.; Cary, J.W.; Calvo, A.M. The role of veA in Aspergillus flavus infection of peanut, corn and cotton. Open Mycol. J. 2009, 3, 27–36. [Google Scholar] [CrossRef]
- Chang, P.K.; Scharfenstein, L.L.; Wei, Q.; Bhatnagar, D. Development and refinement of a high-efficiency gene-targeting system for Aspergillus flavus. J. Microbiol. Methods 2010, 81, 240–246. [Google Scholar] [CrossRef] [PubMed]
- Liu, W.; Xie, Y.; Ma, J.; Luo, X.; Nie, P.; Zuo, Z.; Lahrmann, U.; Zhao, Q.; Zheng, Y.; Zhao, Y.; et al. IBS: An illustrator for the presentation and visualization of biological sequences. Bioinformatics 2015, 31, 3359–3361. [Google Scholar] [CrossRef] [PubMed]
- Kumar, S.; Stecher, G.; Tamura, K. MEGA7: Molecular evolutionary genetics analysis version 7.0 for bigger datasets. Mol. Biol. Evol. 2016, 33, 1870–1874. [Google Scholar] [CrossRef]
- Szewczyk, E.; Nayak, T.; Oakley, C.E.; Edgerton, H.; Xiong, Y.; Taheri-Talesh, N.; Osmani, S.A.; Oakley, B.R. Fusion PCR and gene targeting in Aspergillus nidulans. Nat. Protoc. 2006, 1, 3111–3120. [Google Scholar] [CrossRef] [PubMed]
- Chang, P.K.; Zhang, Q.; Scharfenstein, L.; Mack, B.; Yoshimi, A.; Miyazawa, K.; Abe, K. Aspergillus flavus GPI-anchored protein-encoding ecm33 has a role in growth, development, aflatoxin biosynthesis, and maize infection. Appl. Microbiol. Biotechnol. 2018, 102, 5209–5220. [Google Scholar] [CrossRef] [PubMed]

| Strain/Plasmid | Description | Reference |
|---|---|---|
| Recipient strain | PTS∆ku70∆pyrG | [56] |
| Wild type | PTS∆ku70∆pyrG: AfpyrG | [56] |
| ∆AflrsmA | pyg: ∆AflrsmA: A. flavus ∆ku70 | This study |
| AflrsmAOE | A. fumigatus pyg: gpdA(p):AflrsmA: A. flavus ∆ku70 | This study |
| pWY25.16 | A. fumigatus pyroA:gpdA in pGEMT easy vector | [23] |
| Name | Oligonucleotides Sequence (5’-3’) | Uses |
|---|---|---|
| 133560RT_F | CACAGAACAGAGCAGCGTAG | For RT-PCR |
| 133560RT_R | CTCATGCCCTTGGATTAGG | For RT-PCR |
| actin_F | CAGCCGCTAAGAGTTCCAG | For RT-PCR |
| actin_R | CACCGATCCAAACCGAGTAC | For RT-PCR |
| 133560/5FE_F | GCGTCATGCGAGATTGTTTCC | 5′ flanks amplification and for identification of 83100 mutant |
| 133560/5F_R | GGGTGAAGAGCATTGTTTGAGGCCACTTCCAGAGGCGGAATGCTTC | 5′ flanks amplification |
| 133560/3F_F | GCATCAGTGCCTCCTCTCAGACGGCGTATTCGGTTCACGGTCATAATG | 3′ flanks amplification |
| 133560/3FE_R | GCTACTGGGTCTCAGAGTTGCTTC | 3′ flanks amplification and for identification of 83100 mutant |
| 133560/5F_F | GACGCTGGACACCTGAAACCCAAC | For whole length of KO cassette |
| 133560/3F_R | CCTACTGTACCGATAACATGC | For whole length of KO cassette |
| pyrG_TF | GCCAGTACGAGTGTTGTGGAG | For identification of 133560 mutant |
| pyrG_TR | GTCAGACACAGAATAACTCTC | For identification of 133560 mutant |
| pyrG/F | GCCTCAAACAATGCTCTTCACCC | pyrG amplification |
| pyrG/R | GTCTGAGAGGAGGCACTGATGC | pyrG amplification |
| gpdA/F | GCATCAGTGCCTCCTCTCAGACCATCCGGATGTCGAAGGCTTG | gpdA amplification |
| gpdA/R | GTGTGATGTCTGCTCAAGCG | gpdA amplification |
| RsmA/F | GCTACCCCGCTTGAGCAGACATCACACATGACTCCAGCGAATCG | 133560 ORF amplification |
| RsmA/R | GAGTTTGAGGTGCAGCTGG | 133560 ORF amplification |
| 133560/F | ATGACTCCAGCGCAATCG | For AflrsmA ORF identification |
| 133560L/F | ATGGAGTACCCATACTATCC | For AflrsmA ORF identification |
| 133560/R | TCAGAGAAGGTCATCATCATTAG | For AflrsmA ORF identification |
© 2020 by the authors. Licensee MDPI, Basel, Switzerland. This article is an open access article distributed under the terms and conditions of the Creative Commons Attribution (CC BY) license (http://creativecommons.org/licenses/by/4.0/).
Share and Cite
Wang, X.; Zha, W.; Liang, L.; Fasoyin, O.E.; Wu, L.; Wang, S. The bZIP Transcription Factor AflRsmA Regulates Aflatoxin B1 Biosynthesis, Oxidative Stress Response and Sclerotium Formation in Aspergillus flavus. Toxins 2020, 12, 271. https://doi.org/10.3390/toxins12040271
Wang X, Zha W, Liang L, Fasoyin OE, Wu L, Wang S. The bZIP Transcription Factor AflRsmA Regulates Aflatoxin B1 Biosynthesis, Oxidative Stress Response and Sclerotium Formation in Aspergillus flavus. Toxins. 2020; 12(4):271. https://doi.org/10.3390/toxins12040271
Chicago/Turabian StyleWang, Xiuna, Wenjie Zha, Linlin Liang, Opemipo Esther Fasoyin, Lihan Wu, and Shihua Wang. 2020. "The bZIP Transcription Factor AflRsmA Regulates Aflatoxin B1 Biosynthesis, Oxidative Stress Response and Sclerotium Formation in Aspergillus flavus" Toxins 12, no. 4: 271. https://doi.org/10.3390/toxins12040271
APA StyleWang, X., Zha, W., Liang, L., Fasoyin, O. E., Wu, L., & Wang, S. (2020). The bZIP Transcription Factor AflRsmA Regulates Aflatoxin B1 Biosynthesis, Oxidative Stress Response and Sclerotium Formation in Aspergillus flavus. Toxins, 12(4), 271. https://doi.org/10.3390/toxins12040271





